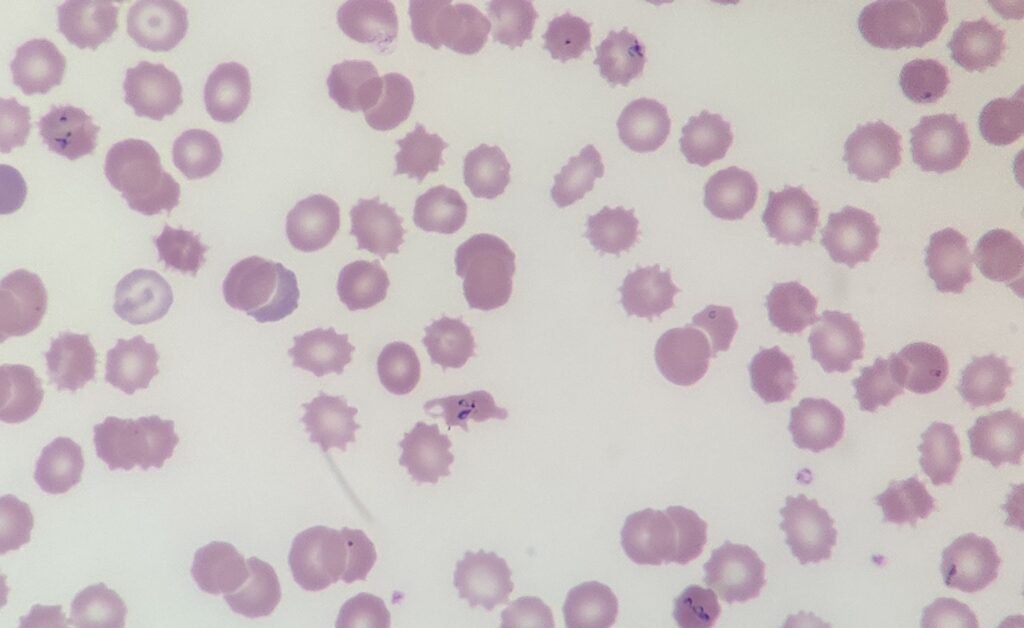
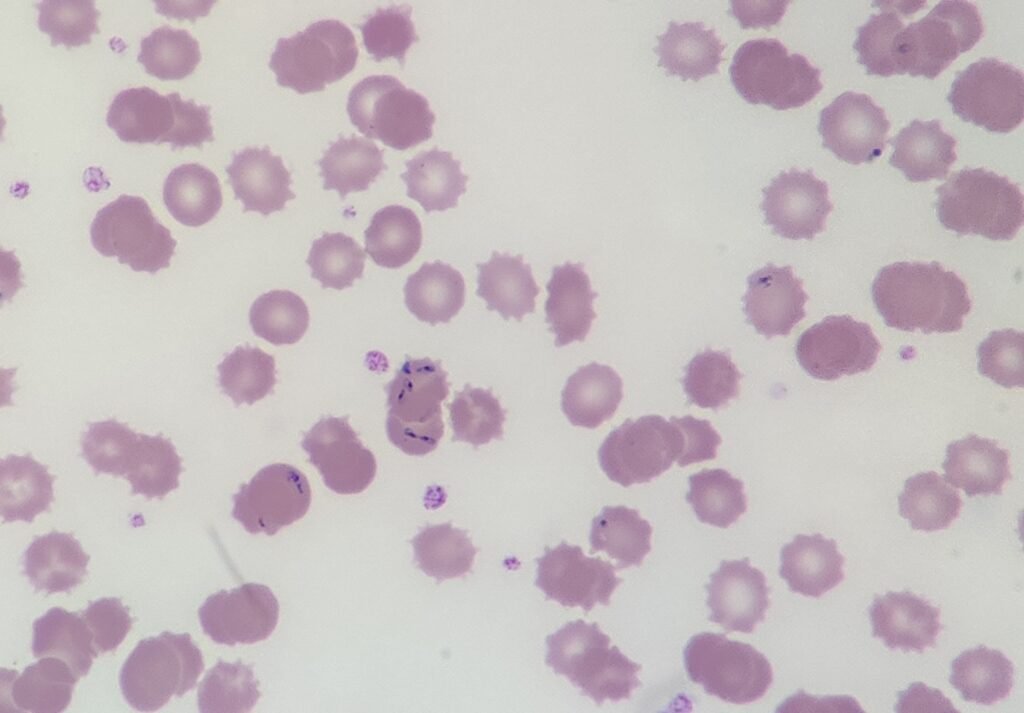

This week’s case involves a 58-year-old patient who presented to the Emergency Department with a five-day history of worsening “flu-like” symptoms, including high fevers, drenching sweats, and significant fatigue. The patient is an avid hiker who recently returned to the UK following a three-week holiday in Nantucket, Massachusetts. They recall several insect bites during their trip but did not think much of them at the time.
Laboratory Results:
- Hb: 92 g/L
- PLT: 88 x109/L
- Bilirubin: Elevated (Unconjugated)
- LDH: Significantly raised
- Reticulocytes: Raised
Blood Film:

Given the patient’s travel history to the Northeast US, what do you think the diagnosis could be?
Feel free to join in the comments or on LinkedIn or Twitter (X).